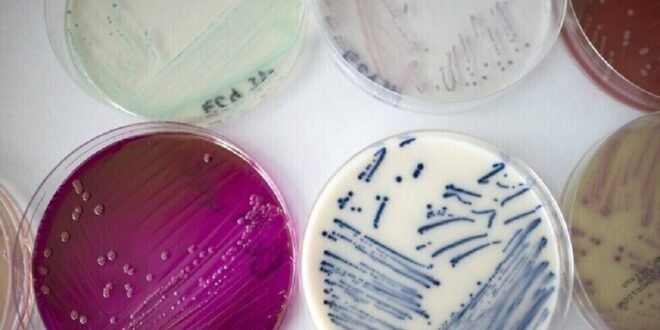

منبر العراق الحر :
كشفت أحدث التقديرات العلمية الجدلية أن حوالي 3.8 مليون شخص يموتون حول العالم بسبب الالتهابات الفطرية سنويا.
ولوضع هذا في الاعتبار، فهو يمثل حوالي 6.8% من إجمالي الوفيات العالمية. ومن المحتمل أن تكون أمراض القلب التاجية مسؤولة عن 16% من إجمالي الوفيات في العالم، تليها السكتة الدماغية بنسبة 11%.
ويشكل مرض الرئة المرتبط بالدخان (COPD) 6% من إجمالي الوفيات، حيث تكون العدوى الفطرية مسؤولة عن حوالي ثلث هذه الوفيات البالغ عددها 3228000.
وللوصول إلى هذه التقديرات المنشورة في مجلة لانسيت للأمراض المعدية، أصدر الخبراء حكما بشأن نسبة الحالات الفطرية التي تم تشخيصها وعلاجها بالفعل، وتلك التي لم يتم تشخيصها. وفي حين تحسن تشخيص الأمراض الفطرية بشكل كبير في السنوات العشر إلى الخمس عشرة الماضية، فإن الوصول إلى هذه الاختبارات واستخدامها الفعلي محدود، وليس فقط في البلدان المنخفضة الدخل.
على سبيل المثال، تتمتع جنوب إفريقيا بخدمة تشخيصية تحسد عليها لالتهاب السحايا الفطري والعدوى الفطرية في مجرى الدم (المبيضات)، ولكن لا يوجد لديها تشخيص للعدوى الناجمة عن فطر شائع آخر، وهو فطر Aspergillus. وتساهم هذه الفجوات بشكل كبير في الوفيات غير الضرورية.
وتضم أهم الفطريات القاتلة Aspergillus fumigatus وAspergillus flavus، والتي تسبب التهابات الرئة.
ويموت الكثير من الأشخاص لأن طبيبهم لم يدرك إصابتهم بمرض فطري، أو لأنهم اكتشفوا ذلك بعد فوات الأوان. ولكن العديد من الوفيات ترجع إلى بطء الاختبارات التشخيصية أو غيابها ونقص الأدوية المضادة للفطريات الفعالة.
ولسوء الحظ، كما هو الحال مع مقاومة المضادات الحيوية، فإن مقاومة مضادات الفطريات تمثل مشكلة متنامية أيضا. ويؤدي رش المحاصيل بأنواع معينة من مبيدات الفطريات إلى زيادة كبيرة في معدلات المقاومة لمجموعة من الأدوية المضادة للفطريات، المعروفة باسم الآزولات.
تعد عدوى المبيضات (Candida) أحد أسباب الإنتان وتوجد في مجرى الدم. وترتبط أيضا بمرض السكري أو الفشل الكلوي – أو كليهما – ويمكن أن تستمر أيضا بعد إجراء عملية جراحية كبرى أو صدمة.
ومع إصابة أكثر من 1.5 مليون شخص على مستوى العالم بعدوى المبيضات التي تهدد حياتهم، وما يقرب من مليون حالة وفاة سنويا، فإننا بحاجة ماسة إلى اختبارات تشخيصية أفضل.
وتعزى حوالي 50% من زهاء 600000 حالة وفاة بسبب الإيدز إلى الالتهابات الفطرية.
وسجل العالم أول تفشي واسع النطاق للفطار المخاطي في العالم بعد “كوفيد” في الهند، فيما يسمى بالفطريات السوداء، التي تمنع إمداد الأنسجة بالدم ما يسبب الأنسجة الميتة، ومن هنا الاسم الشائع “الفطر الأسود”.
وهناك أيضا ارتباط قوي بين الحساسية الفطرية والربو الحاد أو الذي لا يمكن السيطرة عليه بشكل جيد.
وعلى الرغم من كل الجهود المبذولة للسيطرة على الربو، فإن ما يقدر بنحو 461000 شخص يموتون بسببه كل عام في جميع أنحاء العالم.
التقرير من إعداد ديفيد دبليو دينينغ، الباحث الرئيسي في مجموعة مانشستر للعدوى الفطرية، جامعة مانشستر.
المصدر: ساينس ألرت
 منبر العراق الحر منبر العراق الحر
منبر العراق الحر منبر العراق الحر